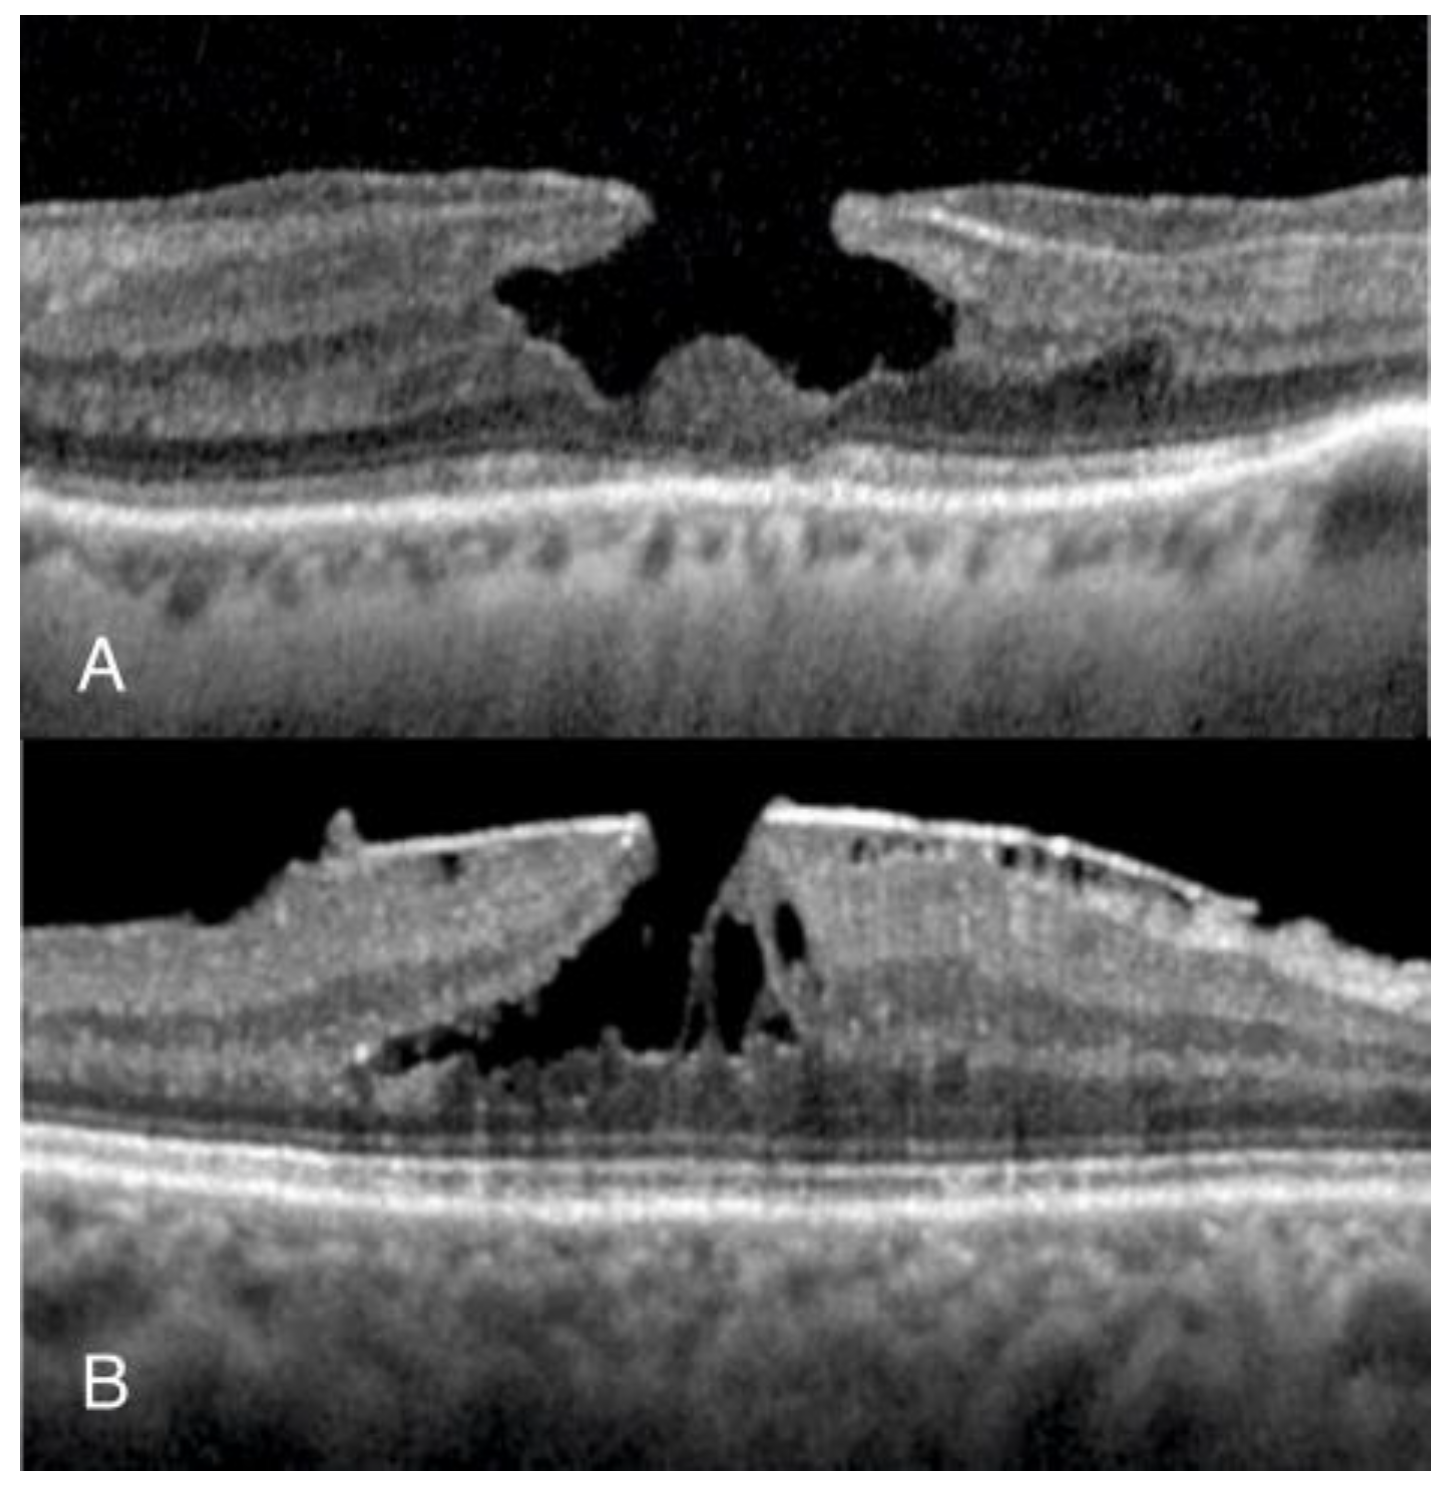
Jcm 13 04620 g001

Novel Method to Measure Volumes of Retinal Specific Entities
Abstract
1. Introduction
2. Materials and Methods
2.1. Data Acquisition—General Protocol
2.2. Data Acquisition in the NFP Group
2.3. Data Acquisition in the LMH Group
2.4. Statistical Analysis
3. Results
4. Discussion
Author Contributions
Funding
Institutional Review Board Statement
Informed Consent Statement
Data Availability Statement
Conflicts of Interest
References
- Taşlıpınar Uzel, A.G.; Gelisken, F.; Kühlewein, L.; Neubauer, J. Volumetric Analysis of Lamellar Macular Hole: An Optical Coherence Tomography Study. Retina 2023, 43, 209–214. [Google Scholar] [CrossRef] [PubMed]
- Pi, S.; Hormel, T.T.; Wang, B.; Bailey, S.T.; Hwang, T.S.; Huang, D.; Morrison, J.C.; Jia, Y. Volume-based, layer-independent, disease-agnostic detection of abnormal retinal reflectivity, nonperfusion, and neovascularization using structural and angiographic OCT. Biomed. Opt. Express. BOE 2022, 13, 4889–4906. [Google Scholar] [CrossRef] [PubMed]
- El Habib Daho, M.; Li, Y.; Zeghlache, R.; Boité, H.L.; Deman, P.; Borderie, L.; Ren, H.; Mannivanan, N.; Lepicard, C.; Cochener, B.; et al. DISCOVER: 2-D multiview summarization of Optical Coherence Tomography Angiography for automatic diabetic retinopathy diagnosis. Artif. Intell. Med. 2024, 149, 102803. [Google Scholar] [CrossRef] [PubMed]
- Nipp, G.E.; Sarici, K.; Lee, T.; Hadziahmetovic, M. Risk factors for worsening morphology and visual acuity in eyes with adult-onset foveomacular vitelliform dystrophy. Ophthalmol. Retin. 2024, 8, 804–812. [Google Scholar] [CrossRef] [PubMed]
- von der Burchard, C.; Treumer, F.; Ehlken, C.; Koinzer, S.; Purtskhvanidze, K.; Tode, J.; Tode, J.; Roider, J. Retinal volume change is a reliable OCT biomarker for disease activity in neovascular AMD. Graefes Arch. Clin. Exp. Ophthalmol. 2018, 256, 1623–1629. [Google Scholar] [CrossRef] [PubMed]
- Guo, Y.; Hormel, T.T.; Xiong, H.; Wang, J.; Hwang, T.S.; Jia, Y. Automated Segmentation of Retinal Fluid Volumes from Structural and Angiographic Optical Coherence Tomography Using Deep Learning. Transl. Vis. Sci. Technol. 2020, 9, 54. [Google Scholar] [CrossRef] [PubMed]
- Balk, L.J.; Coric, D.; Knier, B.; Zimmermann, H.G.; Behbehani, R.; Alroughani, R.; Martinez-Lapiscina, E.H.; Brandt, A.U.; Sánchez-Dalmau, B.; Vidal-Jordana, A.; et al. Retinal inner nuclear layer volume reflects inflammatory disease activity in multiple sclerosis; a longitudinal OCT study. Mult. Scler. J.-Exp. Transl. Clin. 2019, 5, 2055217319871582. [Google Scholar] [CrossRef] [PubMed]
- Nam, K.T.; Yun, C.; Lee, Y.J.; Choi, M.; Kang, D.; Oh, J. Visual Outcome and Fluid Changes between Eyes with Polypoidal Choroidal Vasculopathy Receiving Biosimilar CKD-701 or Reference Ranibizumab Therapy: A Post Hoc Analysis of a Phase 3 Randomized Clinical Trial. Curr. Eye Res. 2024, 49, 663–670. [Google Scholar] [CrossRef] [PubMed]
- Schmidt-Erfurth, U.; Mulyukov, Z.; Gerendas, B.S.S.; Margaron, P.; Lorand, D.; Bogunovic, H.; Weissgerber, G. A comparison of the therapeutic response between brolucizumab and aflibercept in the HAWK & HARRIER trials using deep learning-based OCT analysis. Investig. Ophthalmol. Vis. Sci. 2020, 61, 1159. [Google Scholar]
- Waldstein, S.M.; Philip, A.M.; Leitner, R.; Simader, C.; Langs, G.; Gerendas, B.S.; Schmidt-Erfurth, U. Correlation of 3-Dimensionally Quantified Intraretinal and Subretinal Fluid With Visual Acuity in Neovascular Age-Related Macular Degeneration. JAMA Ophthalmol. 2016, 134, 182–190. [Google Scholar] [CrossRef]
- Lee, H.; Jo, A.; Kim, H.C. Three-Dimensional Analysis of Morphologic Changes and Visual Outcomes in Neovascular Age-Related Macular Degeneration. Investig. Opthalmol. Vis. Sci. 2017, 58, 1337–1345. [Google Scholar] [CrossRef]
- Rommel, F.; Brinkmann, M.P.; Sochurek, J.A.M.; Prasuhn, M.; Grisanti, S.; Ranjbar, M. Ocular Blood Flow Changes Impact Visual Acuity Gain after Surgical Treatment for Idiopathic Epiretinal Membrane. J. Clin. Med. 2020, 9, 1768. [Google Scholar] [CrossRef]
- Aumann, S.; Donner, S.; Fischer, J.; Müller, F. Optical Coherence Tomography (OCT): Principle and Technical Realization. In High Resolution Imaging in Microscopy and Ophthalmology: New Frontiers in Biomedical Optics; Bille, J.F., Ed.; Springer International Publishing: Cham, Switzerland, 2019; pp. 59–85. [Google Scholar] [CrossRef]
- Zeppieri, M.; Marsili, S.; Enaholo, E.S.; Shuaibu, A.O.; Uwagboe, N.; Salati, C.; Spadea, L.; Musa, M. Optical Coherence Tomography (OCT): A Brief Look at the Uses and Technological Evolution of Ophthalmology. Medicina 2023, 59, 2114. [Google Scholar] [CrossRef]
- Tian, J.; Varga, B.; Tatrai, E.; Fanni, P.; Somfai, G.M.; Smiddy, W.E.; Debuc, D.C. Performance evaluation of automated segmentation software on optical coherence tomography volume data. J. Biophotonics 2016, 9, 478–489. [Google Scholar] [CrossRef]
- Debuc, D. A Review of Algorithms for Segmentation of Retinal Image Data Using Optical Coherence Tomography. Image Segm. 2011, 1, 15–54. [Google Scholar]
- Schlegl, T.; Waldstein, S.M.; Bogunovic, H.; Endstraßer, F.; Sadeghipour, A.; Philip, A.M.; Podkowinski, D.; Gerendas, B.; Langs, G.; Schmidt-Erfurth, U.M. Fully Automated Detection and Quantification of Macular Fluid in OCT Using Deep Learning. Ophthalmology 2018, 125, 549–558. [Google Scholar] [CrossRef]
- Li, M.X.; Yu, S.Q.; Zhang, W.; Zhou, H.; Xu, X.; Qian, T.W.; Wan, Y.-J. Segmentation of retinal fluid based on deep learning: Application of three-dimensional fully convolutional neural networks in optical coherence tomography images. Int. J. Ophthalmol. 2019, 12, 1012–1020. [Google Scholar]
- Miotto, R.; Wang, F.; Wang, S.; Jiang, X.; Dudley, J.T. Deep learning for healthcare: Review, opportunities and challenges. Brief Bioinform. 2017, 19, 1236–1246. [Google Scholar] [CrossRef]
- Hubschman, J.P.; Govetto, A.; Spaide, R.F.; Schumann, R.; Steel, D.; Figueroa, M.S.; Sebag, J.; Gaudric, A.; Staurenghi, G.; Haritoglou, C.; et al. Optical coherence tomography-based consensus definition for lamellar macular hole. Br. J. Ophthalmol. 2020, 104, 1741–1747. [Google Scholar] [CrossRef]
- Moussa, G.; Jalil, A.; Lippera, M.; Alnafisee, N.; Ivanova, T. Factors influencing the reliability of measurements in eyes with full-thickness macular holes. Are we measuring incorrectly? BMJ Open Ophthalmol. 2024. [Google Scholar]
- Bland, J.M.; Altman, D.G. Statistical methods for assessing agreement between two methods of clinical measurement. Lancet 1986, 1, 307–310. [Google Scholar] [CrossRef] [PubMed]
- Meng-Jie, L.; Wei-Hua, Z.; Yu-Xiu, L.; Hua-Zhang, M.; Yong-Chang, L.; Mu-Huo, J. Sample Size for Assessing Agreement between Two Methods of Measurement by Bland-Altman Method. Int. J. Biostat. 2016, 12, 20150039. [Google Scholar] [CrossRef]
- Verticchio Vercellin, A.C.; Jassim, F.; Poon, L.Y.C.; Tsikata, E.; Braaf, B.; Shah, S.; Ben-David, G.; Shieh, E.; Lee, R.; Simavli, H. Diagnostic Capability of Three-Dimensional Macular Parameters for Glaucoma Using Optical Coherence Tomography Volume Scans. Investig. Ophthalmol. Vis. Sci. 2018, 59, 4998–5010. [Google Scholar] [CrossRef] [PubMed]
- Lippera, M.; Moussa, G.; Ivanova, T.; Ferrara, M.; Spiess, K.; Ally, N.; Jasani, K.; Dhawahir-Scala, F.; Patton, N.; Jalil, A. Volumetric Biomarkers of Visual Outcome after Surgical Repair in Lamellar Macular Holes. J. Pers. Med. 2024, 14, 755. [Google Scholar] [CrossRef] [PubMed]
- Kaiser, P.K.; Wykoff, C.C.; Singh, R.P.; Khanani, A.M.; Do, D.V.; Patel, H.; Patel, N. Retinal Fluid and Thickness as Measures of Disease Activity in Neovascular Age-Related Macular Degeneration. Retina 2021, 41, 1579–1586. [Google Scholar] [CrossRef] [PubMed]
- Schneider, M.; Bjerager, J.; Hodzic-Hadzibegovic, D.; Klefter, O.N.; Subhi, Y.; Hajari, J. Short-term outcomes of treatment switch to faricimab in patients with aflibercept-resistant neovascular age-related macular degeneration. Graefes Arch. Clin. Exp. Ophthalmol. 2024, 262, 2153–2162. [Google Scholar] [CrossRef] [PubMed]
- Jiang, X.; Shen, M.; Wang, L.; de Sisternes, L.; Durbin, M.K.; Feuer, W.; Rosenfeld, P.J.; Gregori, G. Validation of a Novel Automated Algorithm to Measure Drusen Volume and Area Using Swept Source Optical Coherence Tomography Angiography. Transl. Vis. Sci. Technol. 2021, 10, 11. [Google Scholar] [CrossRef] [PubMed]
- Hsiao, C.H.; Sun, T.L.; Lin, P.C.; Peng, T.Y.; Chen, Y.H.; Cheng, C.Y.; Yang, F.-J.; Yang, S.-Y.; Wu, C.-H.; Lin, F.Y.-S.; et al. A deep learning-based precision volume calculation approach for kidney and tumor segmentation on computed tomography images. Comput. Methods Programs Biomed. 2022, 221, 106861. [Google Scholar] [CrossRef]
- Bai, F.; Marques, M.J.; Gibson, S.J. Cystoid macular edema segmentation of Optical Coherence Tomography images using fully convolutional neural networks and fully connected CRFs. arXiv 2017, arXiv:1709.05324. [Google Scholar] [CrossRef]

| Type of Comparison | n | Estimate of Bias (mm) | 95% CI (mm) | Lower Limit of Agreement (mm) | 95% CI (mm) | Upper Limit of Agreement (mm) | 95% CI (mm) | Coefficient of Repeatability (mm) |
|---|---|---|---|---|---|---|---|---|
| Intra-observer Total Retinal Volume | ||||||||
| Obs 1, Obs 1 | 30 | 0.0074 | 0.0048 to 0.0100 | −0.0067 | −0.0144 to 0.0010 | 0.0215 | 0.0138 to 0.0292 | 0.0141 |
| Obs 2, Obs 2 | 30 | 0.0066 | 0.0042 to 0.0090 | −0.0066 | −0.0139 to 0.0006 | 0.0198 | 0.0125 to 0.0270 | 0.0132 |
| Inter-observer Total Retinal Volume | ||||||||
| Obs 1-Obs 2 | 30 | −0.0021 | −0.0041 to −0.0001 | −0.0132 | −0.0193 to −0.0071 | 0.0090 | 0.0029 to 0.0151 | 0.0111 |
| Automated-Obs 1 | 30 | −0.0041 | −0.0067 to −0.0015 | −0.0184 | −0.0262 to −0.0106 | 0.0102 | 0.0024 to 0.0180 | 0.0143 |
| Automated-Obs 2 | 30 | −0.0062 | −0.0088 to −0.0036 | −0.0203 | −0.0280 to −0.0126 | 0.0079 | 0.0002 to 0.0156 | 0.0141 |
| Intra-observer Foveal Cavity | ||||||||
| Obs 1, Obs 1 | 32 | −0.0021 | −0.0061 to 0.0020 | −0.0242 | −0.0359 to −0.0125 | 0.0201 | 0.0083 to 0.0318 | 0.0221 |
| Obs 2, Obs 2 | 32 | −0.0048 | −0.0080 to −0.0016 | −0.0222 | −0.0315 to −0.0130 | 0.0126 | 0.0034 to 0.0219 | 0.0174 |
| Inter-observer Foveal Cavity | ||||||||
| Obs 1, Obs 2 | 32 | −0.0004 | −0.0020 to 0.0011 | −0.0088 | −0.0132 to −0.0043 | 0.0079 | 0.0035 to 0.0123 | 0.0083 |
Disclaimer/Publisher’s Note: The statements, opinions and data contained in all publications are solely those of the individual author(s) and contributor(s) and not of MDPI and/or the editor(s). MDPI and/or the editor(s) disclaim responsibility for any injury to people or property resulting from any ideas, methods, instructions or products referred to in the content. |
© 2024 by the authors. Licensee MDPI, Basel, Switzerland. This article is an open access article distributed under the terms and conditions of the Creative Commons Attribution (CC BY) license (https://creativecommons.org/licenses/by/4.0/).
Share and Cite
Lippera, M.; Ferrara, M.; Spiess, K.; Alnafisee, N.; Ally, N.; Jalil, A.; Ivanova, T.; Moussa, G. Novel Method to Measure Volumes of Retinal Specific Entities. J. Clin. Med. 2024, 13, 4620. https://doi.org/10.3390/jcm13164620
Lippera M, Ferrara M, Spiess K, Alnafisee N, Ally N, Jalil A, Ivanova T, Moussa G. Novel Method to Measure Volumes of Retinal Specific Entities. Journal of Clinical Medicine. 2024; 13(16):4620. https://doi.org/10.3390/jcm13164620
Chicago/Turabian StyleLippera, Myrta, Mariantonia Ferrara, Karina Spiess, Nouf Alnafisee, Naseer Ally, Assad Jalil, Tsveta Ivanova, and George Moussa. 2024. "Novel Method to Measure Volumes of Retinal Specific Entities" Journal of Clinical Medicine 13, no. 16: 4620. https://doi.org/10.3390/jcm13164620
APA StyleLippera, M., Ferrara, M., Spiess, K., Alnafisee, N., Ally, N., Jalil, A., Ivanova, T., & Moussa, G. (2024). Novel Method to Measure Volumes of Retinal Specific Entities. Journal of Clinical Medicine, 13(16), 4620. https://doi.org/10.3390/jcm13164620

